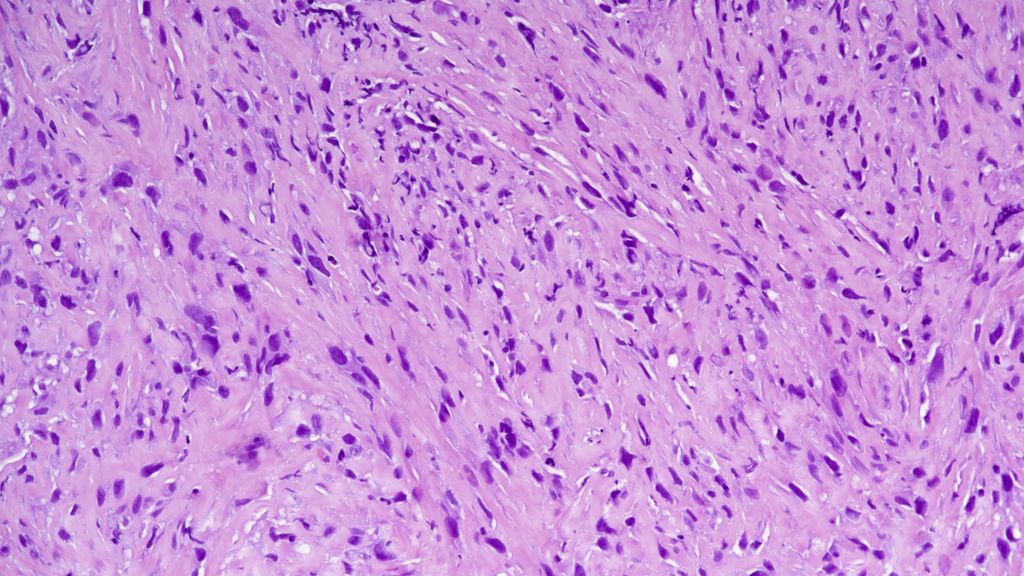

Molekularpathologie in Diagnostik und Therapie
Autor:
Prim. Univ.-Prof. Dr. Sigurd F. Lax
Vorstand des Instituts für Pathologie des Landeskrankenhauses Graz II, Standort West
Akademisches Lehrkrankenhaus der Medizinischen Universität Graz
Professor für Pathologie an der Johannes Kepler Universität Linz
E-Mail: sigurd.lax@kages.at
Die molekularen Veränderungen in unterschiedlichen Schilddrüsentumoren können die Diagnostik unterstützen und werden zunehmend für die Therapie fortgeschrittener und rezidivierter, meist schlecht oder undifferenzierter Karzinome herangezogen.
Keypoints
-
Die meisten histologischen Typen von Schilddrüsenkarzinomen sind durch unterschiedliche molekulare Veränderungen charakterisiert, die die Diagnostik unterstützen können. Follikuläre Karzinome können allerdings nicht von Adenomen und Tumoren unsicherer maligner Potenz unterschieden werden.
-
Die moderne zielgerichtete Therapie und Immuntherapie anaplastischer und schlecht differenzierter Schilddrüsenkarzinome bedürfen einer molekularen Analyse mittels „next-generation sequencing“ (NGS), ergänzt durch standardisierte Immunhistochemie.
-
Die potenzielle Malignität zytologisch auffälliger Schilddrüsenknoten kann mittels molekularer Analysen weiter eingegrenzt werden. Diese Option ist bis dato in Europa und speziell in Österreich kaum verbreitet.
Der Einsatz eines molekularen Biomarkers kann grundsätzlich drei verschiedene Zielrichtungen aufweisen: Hilfestellung bzw. Verbesserung in der Diagnostik (mitunter auch Hilfe bei der Klassifikation eines Tumors), Informationen zur Prognose und schließlich Bestimmung des möglichen Ansprechens auf eine Therapie (prädiktive Analyse).
Auch für Schilddrüsentumoren stehen mittlerweile viel Wissen und Informationen zur Verfügung, die für diese praktischen Ziele eingesetzt werden können. Die wesentliche Basis dafür bleibt aber nach wie vor die histopathologische Klassifikation der Schilddrüsentumoren, die von der WHO in den letzten Jahren neu erstellt und vor Kurzem in Buchform publiziert wurde.1
Die wesentlichste und zahlenmäßig häufigste Gruppe stellen dabei die vom Follikelepithel abstammenden Tumoren dar, bei denen man zwischen gutartigen Tumoren, Tumoren mit einem niedrigen Malignitätsrisiko, niedrig malignen und hoch malignen Tumoren unterscheidet. In der Folge sollen die molekularen Veränderungen für die wesentlichen Gruppen von Schilddrüsentumoren und die praktische Relevanz molekularer Untersuchungen dargestellt werden.
Tumoren des Follikelepithels
Bei den Tumoren des Follikelepithels werden zwei grundsätzliche molekulare Pathways unterschieden: jener von Tumoren mit Alterationen der RAS-Onkogene (als RAS-artige Tumoren bezeichnet) und jener von Tumoren mit BRAFV600E-Mutationen (BRAFV600E-artige Tumoren).1
Die beiden Tumorgruppen unterscheiden sich durch molekulare und histomorphologische Veränderungen. Die wichtigsten Merkmale sind in der Tabelle dargestellt.
Prototypen für die RAS-artigen Tumoren sind das follikuläre Karzinom und die gekapselte follikuläre Variante des papillären Karzinoms. RAS-Mutationen können aber auch in Adenomen und follikulären Tumoren unsicherer maligner Potenz vorkommen, sodass sie für die Dignitätsbestimmung nicht herangezogen werden können.
BRAFV600E-Mutationen sind hingegen typisch für papilläre Karzinome. Sie stellen auch ein Ausschlusskriterium für nichtinvasive follikuläre Tumoren mit papillären Kernveränderungen dar (NIFTP-Tumoren). In follikulären Tumoren finden sich neben RAS-Mutationen auch Rearrangements von PAX8::PPARG, ebenso in der gekapselten follikulären Variante des papillären Karzinoms. In follikulären Adenomen mit papillärer Architektur finden sich in bis zu 70% aktivierende Mutationen des TSH-Rezeptor-Gens, seltener Mutationen von GNAS. Diese Tumoren müssen negativ für BRAFV600E-Mutationen sein.
Onkozytäre Schilddrüsentumoren unterscheiden sich auf der molekularen Ebene von follikulären und papillären Tumoren dadurch, dass ihnen RAS und BRAFV600E-Mutationen fehlen, hingegen häufig Mutationen mitochondrialer DNA vorkommen.
In schlecht differenzierten Schilddrüsenkarzinomen zeigen sich sowohl Mutationen der RAS-Familie als auch von BRAF, zusätzlich Mutationen des TERT-Promoters und TP53-Mutationen. Zudem sind diese prognostisch ungünstigen Schilddrüsenkarzinome durch molekulare Alterationen des PI3K/PTEN/AKT-Pathways charakterisiert. In diesen molekularen Veränderungen ähneln sie den noch aggressiveren anaplastischen Schilddrüsenkarzinomen (Abb. 1). Das anaplastische Schilddrüsenkarzinom zeigt außerdem eine häufige Expression von PD-L1 (in bis zu 70% der Fälle) mit einem CPS von ≥1.2
Abb. 1: Anaplastisches (undifferenziertes) Schilddrüsenkarzinom, aufgebaut aus polymorphen, hochgradig atypischen, spindeligen Zellen. HE, Originalvergrößerung 200-fach
Molekulare Veränderungen beim medullären Schilddrüsenkarzinom
Medulläre Schilddrüsenkarzinome zeigen häufig Mutationen des RET-Gens, davon in mehr als einem Viertel der Fälle im Rahmen einer Keimbahnmutation bzw. eines MEN2-Syndroms. Daher ist mittlerweile die Untersuchung auf Keimbahn-RET-Mutationen für alle Patient:innen mit medullären Schilddrüsenkarzinomen, unabhängig von der Familienanamnese, empfohlen. Daneben sind auch RAS-Mutationen als wesentliche genomische Driver bekannt.
Somatische RET-Mutationen finden sich in mehr als 50% der sporadischen medullären Schilddrüsenkarzinome. RAS-Mutationen (KRAS und HRAS) kommen wechselseitig exklusiv mit den RET-Mutationen vor. Selten finden sich auch Rearrangements von RET oder ALK.
Molekulare Diagnostik als Unterstützung für die Diagnosestellung
Für papilläre Karzinome (mit Ausnahme der bekapselten follikulären Variante) sowie für den Ausschluss des NIFTP ist die Untersuchung auf BRAFV600E-Mutationen wesentlich. Zu diesem Zwecke kann auch die Immunhistochemie mit mutationsspezifischen Antikörpern verwendet werden. Für schlecht differenzierte und anaplastische Karzinome ist die Untersuchung auf abnormes p53-Protein mittels Immunhistochemie bzw. auf TP53-Mutationen mittels Sequenzierung diagnostisch hilfreich. Seltene und insbesondere mesenchymale Tumoren werden mittels „next-generation sequencing“ (NGS) auf mögliche Genfusionen untersucht. Kaum Verwendung finden derzeit Untersuchungen von onkozytären Tumoren auf Veränderungen der mitochondrialen DNA. Follikuläre Adenome, follikuläre Tumoren unsicherer maligner Potenz und follikuläre Karzinome können auf molekularer Ebene derzeit nicht mit Sicherheit voneinander unterschieden werden, daher machen molekulare Untersuchungen keinen Sinn für die Diagnostik.
Für alle seltenen Tumoren in der Schilddrüse, einschließlich mesenchymaler Tumoren und maligner Lymphome, gelten die diagnostischen Grundsätze anderer Lokalisationen. Speziell für ungewöhnliche mesenchymale Tumoren ist eine ausführliche molekulare Analyse schon für die Diagnosestellung hilfreich.
Molekulare Diagnostikfür die Zytologie
Für die Schilddrüsenfunktionszytologie hat sich speziell in den USA die molekulare Diagnostik in der weiteren Abklärung suspekter Biopsien (betreffend die Bethesda-Gruppen III und IV korrespondierend mit den ÖGPath-Gruppen B0 und B1) etabliert. Diese Untersuchungen beruhen auf einer Reihe schon länger zurückliegender wissenschaftlicher Ergebnisse, wobei die Untersuchung eines Mutationspanels (z.B. BRAF, NRAS, HRAS, KRAS, RET/PTC1, RET/PTC3, PAX8/PPARc; diese Untersuchung wird auch als „7-Gene-Panel“ bezeichnet) eine höhere Signifikanz aufweist als eine Einzel-Genanalyse (z.B. BRAF).
Dabei hat sich herausgestellt, dass eine Positivität für BRAF-Mutationen sowie RET/PTC- oder PAX8/PPARc-Fusionen in nahezu 100% für Malignität spricht, während RAS-Mutationen ein 84%iges Risiko für ein follikuläres Karzinom und eine 16%ige Wahrscheinlichkeit für ein follikuläres Adenom in sich bergen.
Die Guidelines der American Thyroid Association für Schilddrüsenknoten und Schilddrüsenkarzinome aus dem Jahr 2015 schlagen prinzipiell die Verwendung molekularer Marker für unklare zytologische Präparate aus der Schilddrüse vor, insbesondere um den Verdacht einer Malignität auszuschließen. Diese Untersuchungen können für die Entscheidungsfindung hinsichtlich eines chirurgischen Vorgehens herangezogen werden.3 Allerdings fehlen Langzeitdaten hinsichtlich der Verwendung molekularer Marker für therapeutische Entscheidungen.
Für die Praxis sollte auch die Möglichkeit einer Wiederholung der Aspirationszytologie in Betracht gezogen werden. Eine eingehende Aufklärung der Patient:innenist dringend erforderlich. Diese Empfehlungen haben nur eine mäßige Evidenz und einen schwachen Empfehlungsgrad. Dasselbe gilt insbesondere für das Heranziehen der molekularen Untersuchungen als Ergänzung für die Entscheidungsfindung hinsichtlich chirurgischer Therapie. Laut ATA-Guidelines sollte entweder BRAF oder das „7-Gene-Panel“ herangezogen werden.3
In einem rezenten Review über den Einsatz der molekularen Diagnostik in Feinnadelaspiraten von Schilddrüsenknoten wurden die Herausforderungen hinsichtlich der Interpretation der Ergebnisse und die sich weiter entwickelnden Testplattformen zur Sprache gebracht.4 Fragen persistieren hinsichtlich der Kosteneffektivität und der Verwendung des Ultraschalls für die Selektion zur molekularen Testung.
Derzeit sind drei unterschiedliche molekulare Plattformen für die Anwendung in der Schilddrüsenzytologie am US-Markt (Afirma GSC, ThyroSeq GC und ThyGeNEXT+ThyraMIR), wobei durch zunehmende Optimierung einzelner Plattformen die positiven und negativen prädiktiven Werte Sensibilität und Spezifität deutlich verbessert wurden.4
Ein alternatives System mit Analyse von zwölf Genen wurde von einer europäischen Firma (IdyllaTM ThyroidPrint® Assay) entwickelt, erfordert derzeit aber noch eine Validierung vor Ort.
In Europa ist die Anwendung der molekularen Diagnostik für die präoperative Abklärung von Schilddrüsenknoten wesentlich weniger verbreitet als in den USA. Im deutschsprachigen Raum und speziell in Österreich wird dieser Methodik derzeit noch mit Skepsis begegnet.
Zielgerichtete Therapie bei anaplastischen und differenzierten Schilddrüsenkarzinomen
Speziell für die hochaggressiven anaplastischen Schilddrüsenkarzinome gibt es mehrere therapeutische Ansätze, die auch in die ATA-Guidelines eingegangen sind.5 Dazu zählen die Immuncheckpoint-Inhibitoren, aber auch eine Reihe weiterer kleiner Moleküle, insbesondere bei der Blockade von BRAFV600E-Mutationen. Auch Fusionen von RET, ALK und NTRAK können zielgerichtet therapiert werden.6 Hingegen gibt es für TERT-, RAS- und TP53-Mutationen keinen therapeutischen Ansatz. Die molekulare Diagnostik anaplastischer und fortgeschrittener differenzierter, speziell schlecht differenzierter Schilddrüsenkarzinome gewinnt aber zunehmend an Bedeutung.7
Diagnostische Molekularpathologie von Schilddrüsentumoren im Alltag
Im klinischen Alltag wird die Diagnostik im Falle einer geplanten Therapie bei „high-grade“ oder anaplastischen Schilddrüsenkarzinomen oder gut differenzierten Schilddrüsenkarzinomen im fortgeschrittenen Stadium auf Basis einer Entscheidung des Tumorboards analysiert. Methode der Wahl sind NGS-Panels, die BRAF- und KRAS-Mutationen sowie ALK-, TRK- und RET-Fusionen detektieren. Zusätzlich kann die PD-L1-Immunhistochemie mittels CPS-Scores durchgeführt werden. Bei ungünstig verlaufenden Fällen besteht immer die Möglichkeit, ein großes Mutationspanel mit mehr als 500 Genen zu analysieren.
Literatur:
1 Endocrine and neuroendocrine tumours. WHO classification of tumours, 5th edition, volume 10. Lyon (France), 2025: WHO Classification of Tumours Editorial Board 2 Agarwal S et al.: PD-L1 expression and its modulating factors in anaplastic thyroid carcinoma: a multi-institutional study. Am J Surg Pathol 2024; 48(10): 1233-44 3 Haugen BR et al.: 2015 American Thyroid Association Management Guidelines for adult patients with thyroid nodules and differentiated thyroid cancer: The American Thyroid Association Guidelines Task Force on Thyroid Nodules and Differentiated Thyroid Cancer. Thyroid 2016; 26(1): 1-133 4 Hannoush ZC et al.: Current state of molecular cytology in thyroid nodules: platforms and their diagnostic and theranostic utility. J Clin Med 2024; 13(6) 5 Bible KC et al.: 2021 American Thyroid Association Guidelines for management of patients with anaplastic thyroid cancer. Thyroid 2021; 31(3): 337-86 6 Tunio MA et al.: Modern therapeutic approaches in anaplastic thyroid cancer: a meta-analytic review of randomised and single arm studies on efficacy and survival. Cancers (Basel) 2025; 17(5) 7 Silver Karcioglu A et al.: The American Thyroid Association (ATA) integrates molecular testing into its framework for managing patients with anaplastic thyroid carcinoma (ATC): update on the 2021 ATA ATC guidelines. Cancer Cytopathol 2022; 130(3): 174-80
Das könnte Sie auch interessieren:
Erhaltungstherapie mit Atezolizumab nach adjuvanter Chemotherapie
Die zusätzliche adjuvante Gabe von Atezolizumab nach kompletter Resektion und adjuvanter Chemotherapie führte in der IMpower010-Studie zu einem signifikant verlängerten krankheitsfreien ...
Highlights zu Lymphomen
Assoc.Prof. Dr. Thomas Melchardt, PhD zu diesjährigen Highlights des ASCO und EHA im Bereich der Lymphome, darunter die Ergebnisse der Studien SHINE und ECHELON-1
Aktualisierte Ergebnisse für Blinatumomab bei neu diagnostizierten Patienten
Die Ergebnisse der D-ALBA-Studie bestätigen die Chemotherapie-freie Induktions- und Konsolidierungsstrategie bei erwachsenen Patienten mit Ph+ ALL. Mit einer 3-jährigen ...




